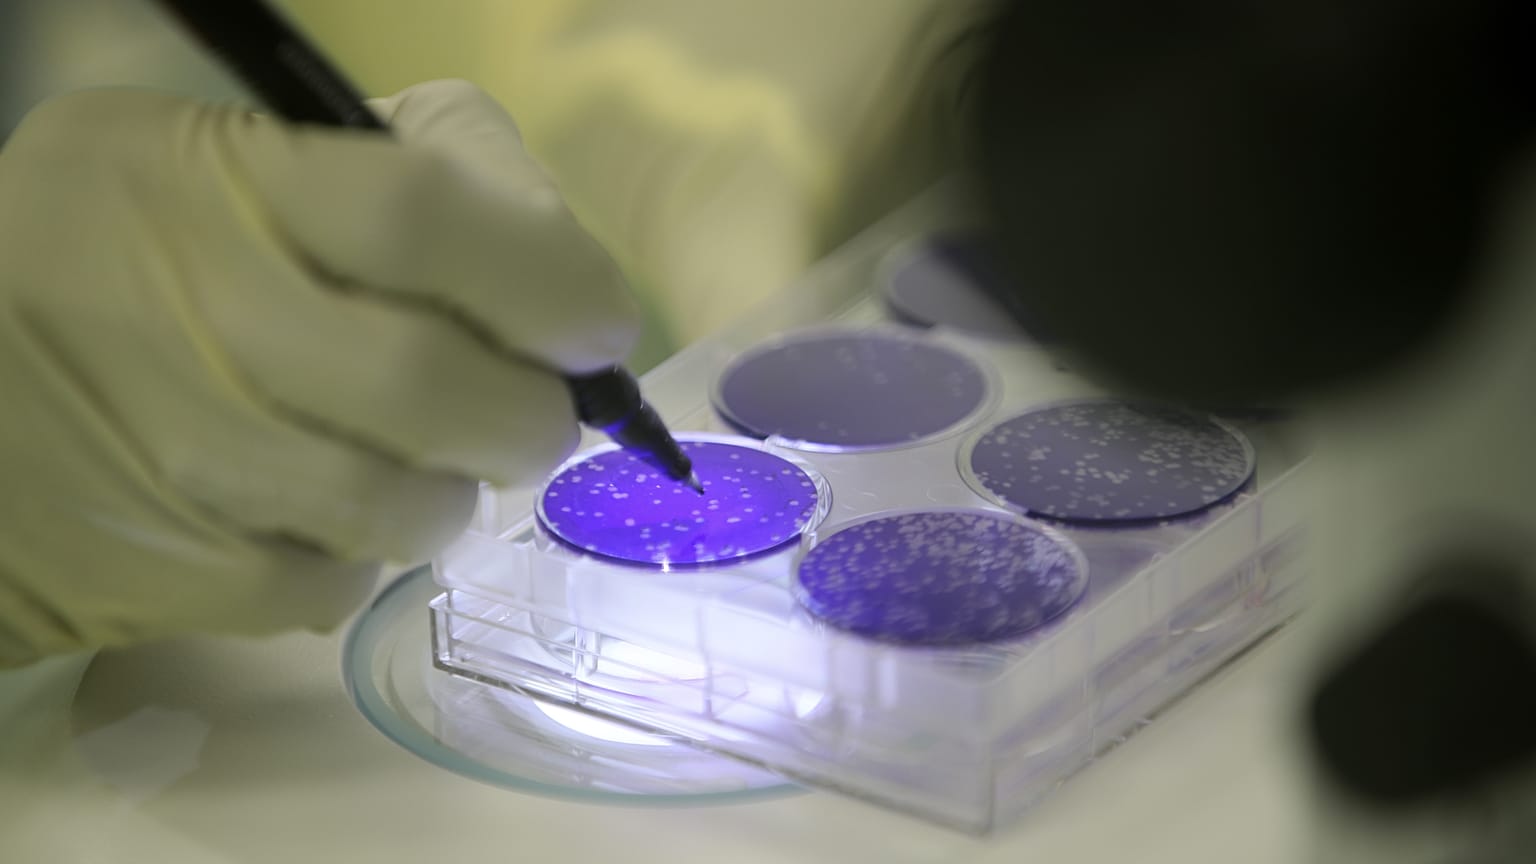
Med4Cure involves 14 projects by 13 companies in six EU countries – Belgium, France, Hungary, Italy, Slovakia, and Spain.

The EU executive approves investment to fill unmet medical needs with a cross-border state aid scheme to develop and test novel drugs as well as advanced therapy products.
The European Commission today (28 May) approved its first Important Project of Common European Interest (IPCEI) in the health sector - dubbed ‘Med4Cure’ - enabling €1bn in public funding across six countries to benefit from lighter touch state aid approvals.
The IPCEI framework provides the Commission with lighter state aid rules to assess public funding of projects involving at least four member states working together on research and development.
Med4Cure involves 14 projects by 13 companies in six EU countries – Belgium, France, Hungary, Italy, Slovakia, and Spain – which will combine to provide up to €1bn in public funding.
The initial public aid allowed by the EU is expected to unlock nearly €6bn in additional private investment to fund the lifetime of projects whose completion is not anticipated before 2036.
“The main scope [of Med4Cure] is to turn scientific knowledge into real innovative treatments for conditions such as diabetes and heart diseases,” Commission Vice-President Margrethe Vestager told reporters, touting the significance of IPCEIs in the EU policy toolbox.
“Med4Cure will support breakthrough innovation in the health space. It focuses on developing treatments for so-called orphan diseases, which affect fewer than 1 in 2000 people,” said Vestager.
One project, for instance, will develop and test advanced therapy products made from human biological material to restore the cornea of patients with visual impairment caused by a rare disease.
The Med4Cure initiative will be focused on different workstreams, from collecting and studying samples of bioresources such as tissues and blood to developing a network of biobanks that could improve the understanding of viruses and various diseases.
Other workstreams will include preclinical models to test novel therapies and diagnostic methods, the validation of vaccines and gene therapies, and the development of more sustainable technologies for producing pharmaceuticals – for instance, to reduce water use in the industrial process.
The Commission has approved nine other IPCEIs since 2018 – including on next-generation cloud services, batteries, microelectronics and the hydrogen value chain.
These projects have involved 22 member states, with the Commission assessing more than 330 projects from nearly 250 companies.